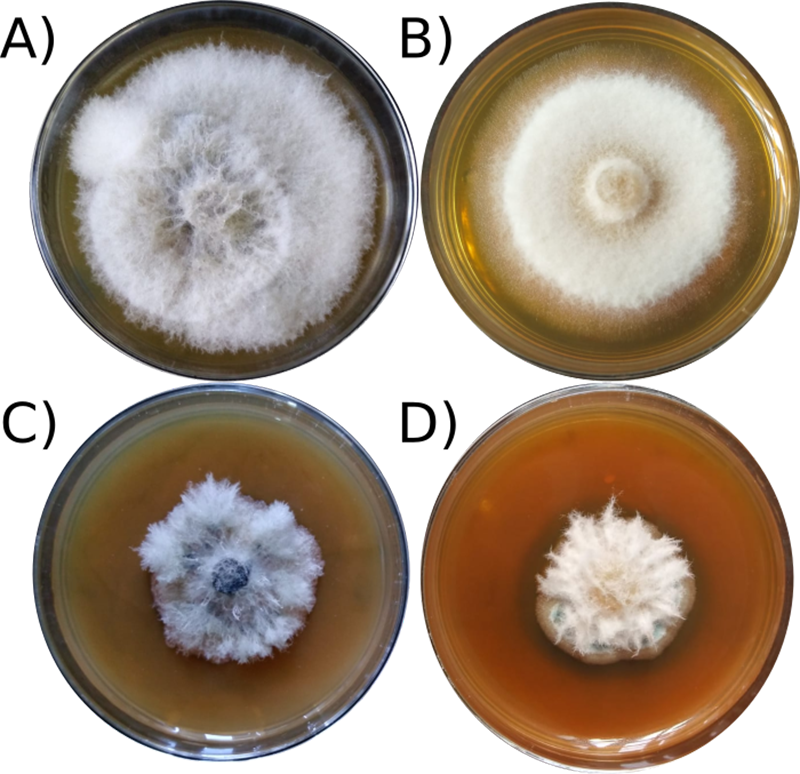

Nanopartículas para el control de hongos patógenos de aguacate
Luis A. Hermida-Montero1,2, Nicolaza Pariona Mendoza1, Iliana C. Ruiz-Leyva2, Zelene Durán-Barradas1, Antonio Solis-Soria1,3, Daniel López-Lima3 y Francisco Paraguay-Delgado2

El uso de las nanopartículas de óxido de zinc es una alternativa para el control de los hongos que afectan a los cultivos de aguacates.
Palabras claves:aguacate, nanopartículas de ZnO, hongos fitopátogenos.
México es el mayor productor, exportador y consumidor de aguacate a nivel mundial y es considerado el centro de origen del aguacate por sus registros históricos de su consumo encontrados en una cueva de Coxcatlán, Puebla que data de 7,000 a 8,000 años a.C. Actualmente, los principales productores nacionales son Michoacán, Jalisco y el Estado de México generando entre ellos el 85% de la producción total nacional. En el 2021 se produjo cerca de 2.5 toneladas; siendo el aguacate tipo Hass, la principal variedad consumida a nivel mundial y de manera local. Sin embargo, entre de los problemas más importantes a los que se enfrenta este cultivo son las enfermedades causadas por hongos.
Los hongos pueden causar enfermedades vasculares, es decir dañan las estructuras que permiten la absorción y transporte de nutrientes del suelo a la planta. Por lo tanto, la planta se debilita, se afecta la producción provocando pérdidas económicas. Por ejemplo, la enfermedad conocida como “Tristeza del aguacatero” (Figura 1) es ocasionada por el hongo del género Neofusicoccum. Este hongo forma parte de un complejo de hongos responsables del retraso en el crecimiento, amarillamiento y en casos severos la muerte de la planta. Así mismo, las enfermedades en los frutos de aguacates pueden afectar la calidad y la cantidad de la cosecha. Especies del hongo del género Colletotrichum afectan los frutos en pre y poscosechas. Estos hongos causan anillamiento del pedúnculo (ocasiona la caída temprana del fruto) y antracnosis del aguacate (obscurecimiento y pudrición del fruto) (Figura 1). Para el control de estas enfermedades ha sido necesario el uso de agroquímicos, cuyo uso conlleva problemas de contaminación ambiental, generación de resistencia de los hongos a los agroquímicos, entre otros.

Enfermedades del aguacate generadas por hongos. (Imagen: Iliana C. Ruiz Leyva y Luis A. Hermida-Montero)
Una alternativa a los fungicidas comunes es el uso de la nanotecnología, la cual se dedica al diseño y manipulación de materia a un nivel muy pequeño, invisible al ojo humano. Para ser específicos, son materiales con dimensiones que fluctúan entre 1 y 100 nanómetros (nm) (siendo 1 nm una billonésima parte de un metro). El tamaño a esta escala les otorga nuevas y mejores propiedades a los materiales, por lo que pueden ser aplicados en diversas áreas; tales como medicina, electrónica, ambiental y la agricultura. Una de las propiedades de interés, es la actividad antimicrobiana de las nanopartículas (NPs) de metales puros u óxidos metálicos de la plata, oro, cobre, vanadio, zinc, entre otros. El mecanismo de acción de estas NPs sobre los microorganismos es mediante la generación de especies reactivas de oxígeno, compuestos químicos inestables, que pueden reaccionar con varias moléculas de las células y causan daño en la pared celular, enzimas, proteínas, ADN, etc. La actividad antimicrobiana de las NPs dependerá del tamaño, forma y composición química (ejemplo; Ag, CuO, ZnO).
Las NPs de óxido de zinc (ZnO) pueden tener una gran variedad de tamaños y formas, los cuales dependen del tipo de proceso y las condiciones que se utilicen para prepararlos. Por ejemplo, en la figura 2 se pueden observar NPs de ZnO en forma de láminas con diámetros que varían entre 50 y 600 nm aproximadamente y un grosor homogéneo de 10 nm. Además de la forma de láminas, la NPs de ZnO también pueden ser esferas, prismas, pirámides, entre otros. Los cuales dependerá de algunos factores del proceso de obtención, como la temperatura, pH, presión, entre otros. Las NPs de ZnO ya se utilizan como agente antimicrobiano incluidos en cremas de aplicación médica ya que se considera un compuesto de baja toxicidad para el ser humano. Así mismo, estás NPs de ZnO han demostrado tener gran capacidad antifúngica contra hongos patógenos de plantas agrícolas, además de promover el crecimiento de las plantas.
En el laboratorio de Agro-nanotecnología del Instituto de Ecología, A.C. (INECOL) en colaboración con el Centro de Investigación de Materiales Avanzados (CIMAV) y la Universidad Veracruzana (UV) se viene trabajando en el desarrollo de NPs de óxidos metálicos con propiedades antifúngicas para el control de hongos patógenos de plantas agrícolas. Entre las NPs que se ha desarrollado están las NPs de ZnO, los cual han demostrado tener potencial para el control de hongos de patógenos de plantas. Por ejemplo, se ha visto que al usar una concentración de 1 mg/mL de NPs de ZnO, las especies de C. gloeosporioides y N. arbuti crecen menos del 30% en relación con los hongos sanos (Figura 3). Estos resultados sugieren que las NPs de ZnO tienen potencial para su uso como fungicida en cultivos de aguacate. En un futuro, se espera utilizar la nanotecnología para mejorar la producción, no sólo del aguacate, sino de todos los cultivos que son importantes para la alimentación.
Agradecimientos: Le agradecemos al CIMAV por el apoyo financiero proporcionado a través del de la convocatoria de Proyectos Internos y al INECOL por apoyos diversos.
C. gloeosporioides (A) y N. arbuti (B) sanos. C. gloeosporioides (C) y N. arbuti (D)expuestos a 1 mg/mL de NPs de óxido de zinc (ZnO). (Imagen: Luis A. Hermida Montero)
1 Red de Estudios Moleculares Avanzados, Instituto de Ecología A.C.
2 Laboratorio Nacional de Nanotecnología, Centro de Investigación en Materiales Avanzados S.C. (CIMAV).
3 Facultad de Ciencias Agrícolas, Universidad Veracruzana.